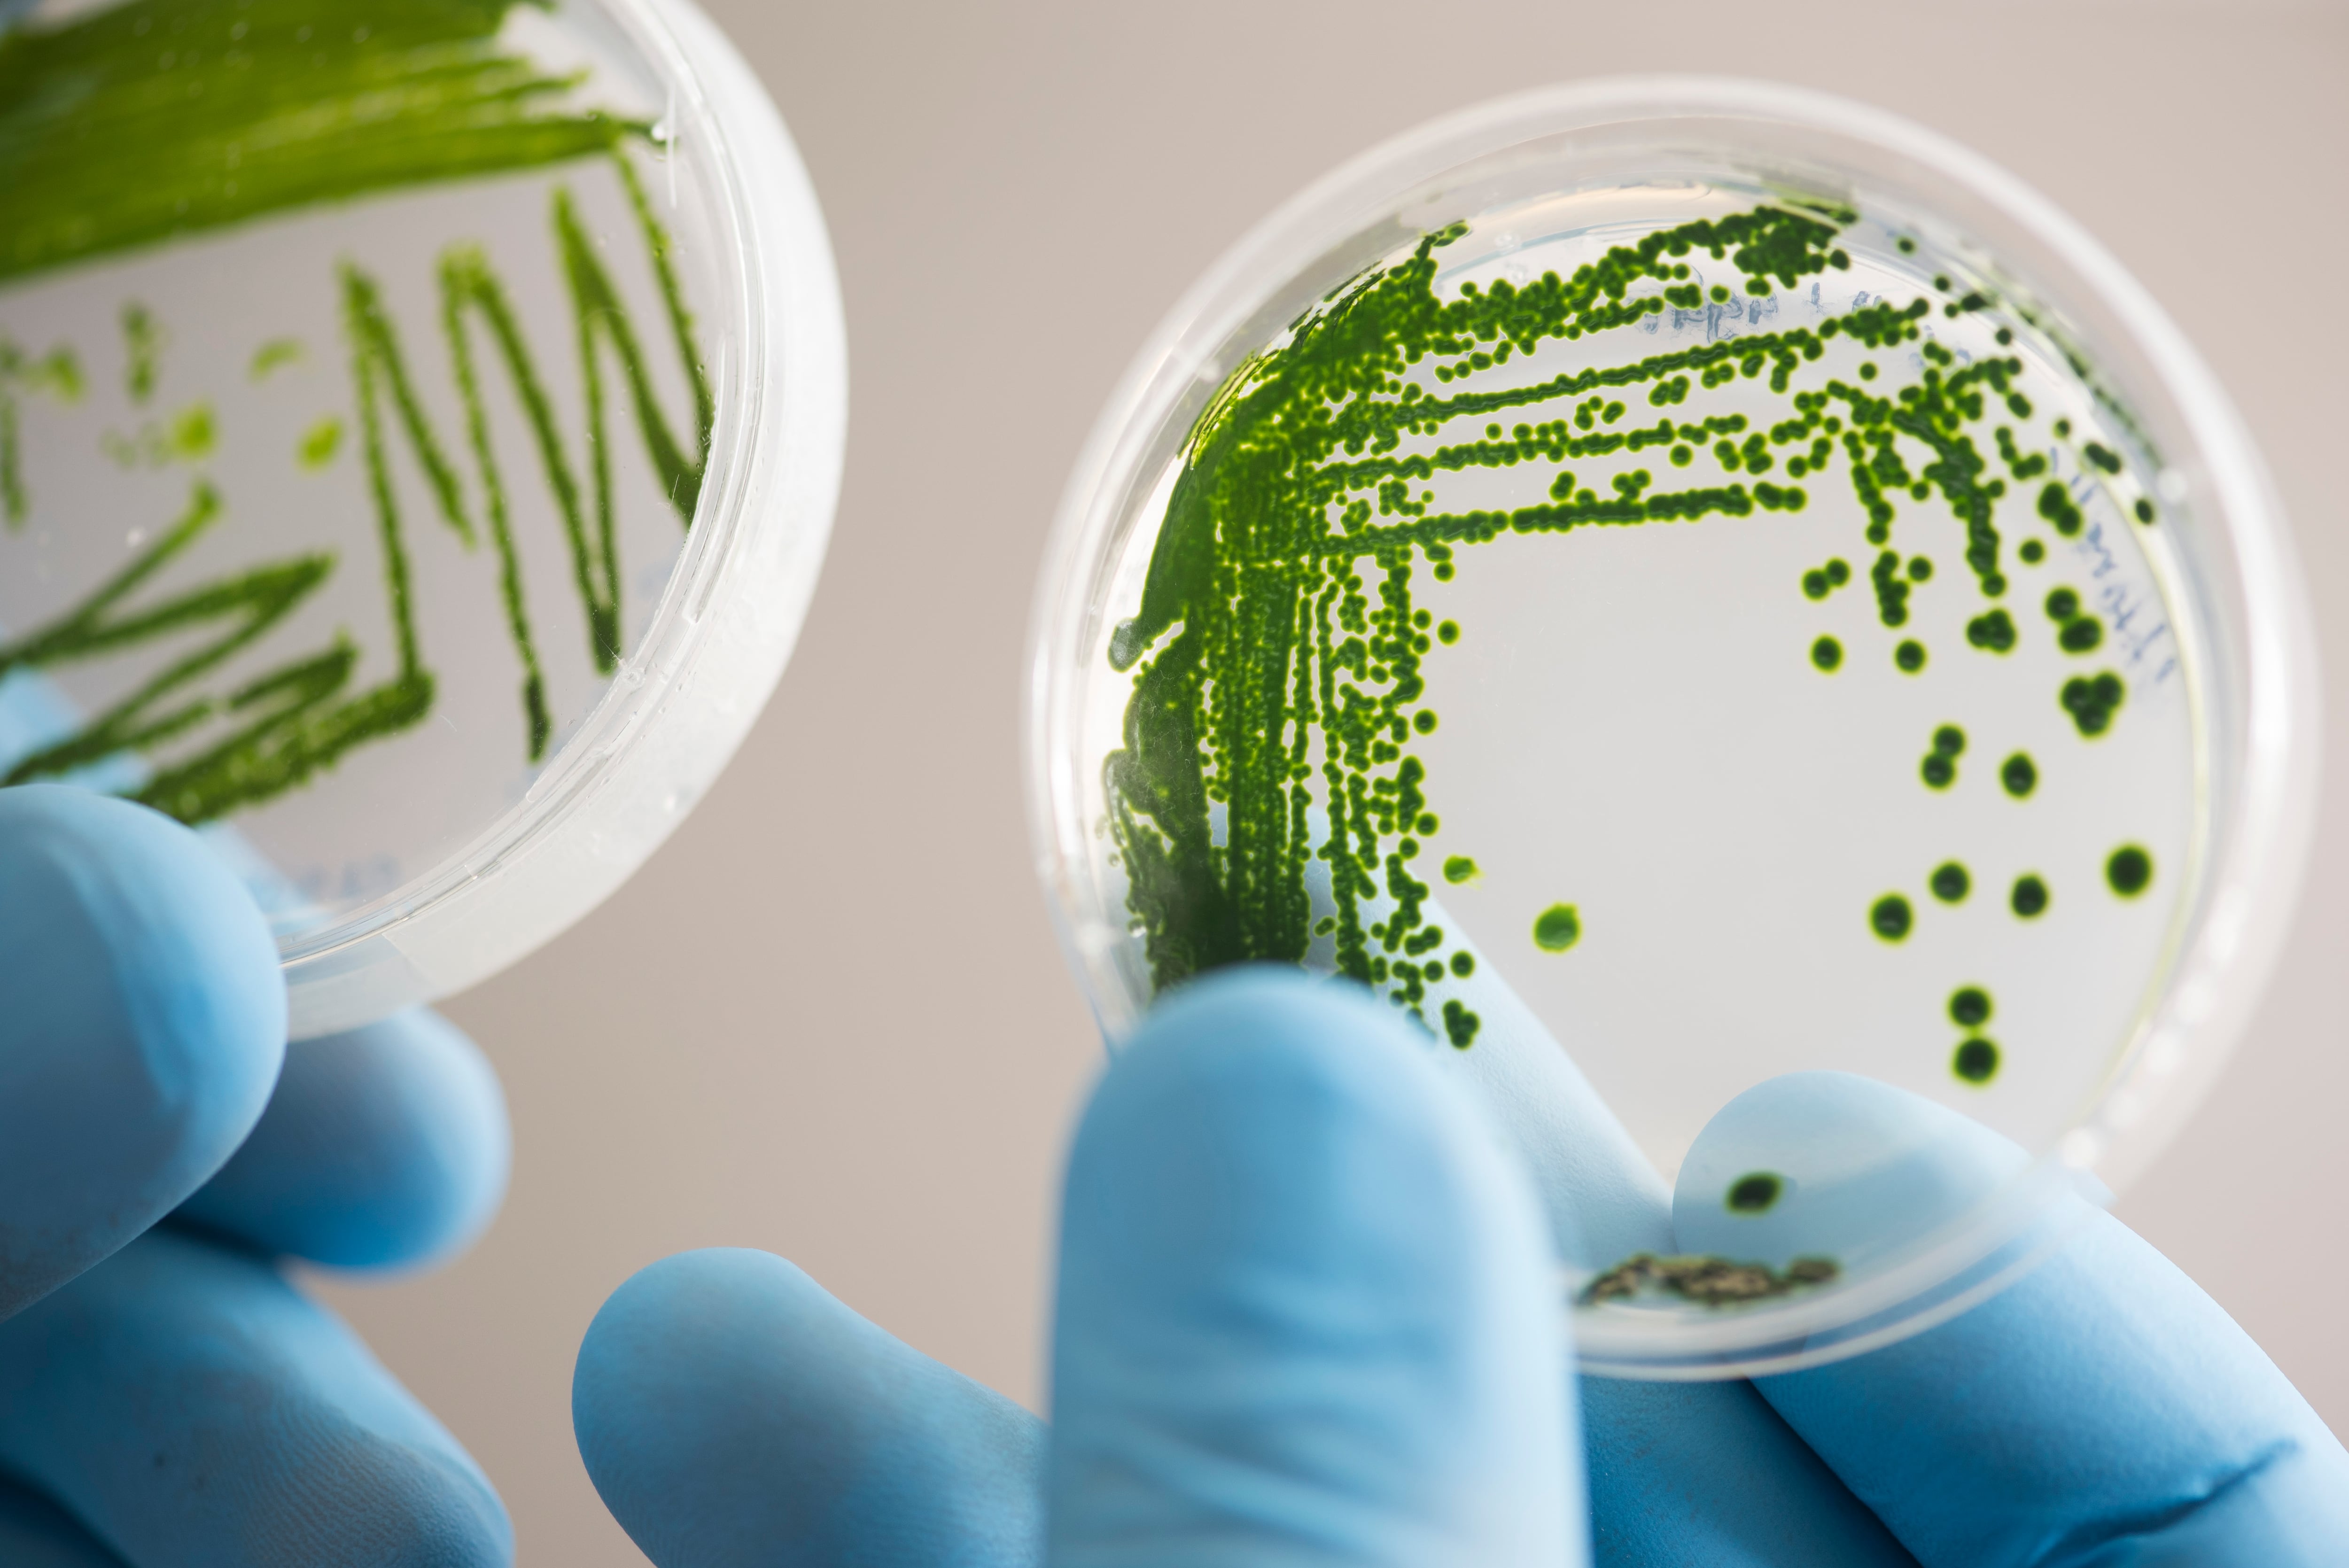

Luis Barboza, cofundador y CEO de la start up Hemoalgae está convencido de que hoy la biotecnología facilita la producción de compuestos para fármacos, cosméticos y agroindustria, pero que antes no se podían producir o tenían un costo elevado.
Por eso, junto a su equipo desarrolla un anticoagulante natural que se encuentra en las sanguijuelas, la hirudina. Precisamente el proceso de producción de Hemoalgae, es parte de las herramientas que ofrece la bioeconomía para que las empresas y emprendimientos se desarrollen en armonía con el ambiente.
El concepto de bioeconomía es definido por la Comisión Económica para América Latina y el Caribe (Cepal) como una economía basada en el consumo y la producción de bienes y servicios en la que se aprovecha el conocimiento de los sistemas, tecnologías, procesos y principios biológicos, según su informe titulado Bioeconomía: oportunidades y desafíos para el desarrollo rural, agrícola y agroindustrial para América Latina y el Caribe.

Barboza explicó que compran “un fragmentito” del ADN de las sanguijuelas y después, mediante técnicas biotecnológicas la insertan dentro de la microalga para que produzca la hirudina. Luego, esas microalgas las hacen crecer en un cultivo, donde las concentran y rompen para extraer el compuesto de interés y finalmente envasarlo. El proceso tiene como resultado una alternativa para el tratamiento de la trombosis (coágulo en venas o arterias).
Aprovechar al máximo los recursos y principios biológicos para la creación de productos es una meta fijada por empresas en el país. A esta dinámica de producción se suman fincas de ganado vacuno y porcino que se autoabastecen por medio de la transformación de materiales biológicos disponibles en el mismo lugar de trabajo.
“Para que sea bioeconomía tiene que tener un origen biológico. Lo que estamos haciendo diferente es que estamos produciendo sustitutos de productos que anteriormente eran de recursos fósiles; estamos cambiando la matriz energética de los territorios”, señaló Hugo Chavarría, coordinador del Programa de Bioeconomía y Desarrollo Productivo del Instituto Interamericano de Cooperación para la Agricultura (IICA).
La empresa Porcina Americana implementó en su finca –en Coris de Cartago– prácticas de la bioeconomía sin saber que dicha medida era de este modelo. Sus responsables fueron motivados por una solución amigable con el ambiente: un biodigestor. La idea inicial era que este minimizara un problema de manejo de excretas de los cerdos de la finca.
“Por medio de la oxidación que toda esa materia orgánica produce, entre otras cosas, metano o biogás es que se alimenta el biodigestor. Ese metano lo usamos como gas de combustión para un motor de generación que produce suficiente energía eléctrica para satisfacer una buena parte de las necesidades de la granja”, explicó Javier Vargas, director Servicios y Proyectos de Porcina Americana.
Vargas asegura con el biodigestor el consumo de energía de la red pública se redujo en un 66% y su facturación pasó de ¢13.345.000 sin biodigestor, a ¢7.110.000 con el dispositivo. Además, trabajan en un convenio con el Tecnológico de Costa Rica (TEC) con el fin de sembrar microalgas en la finca para que sirvan como sustituto de alimento para los cerdos; también pretenden utilizarlas para generar lodos en las aguas residuales que sirvan para purificarlas. Estas plantas metabolizan los contaminantes.
Además del sector pecuario y salud, la agricultura también puede alcanzar la bioeconomía. En el Rinconcito Orgánico Irazú tienen claras las consecuencias que le trae a los suelos y al ambiente en general el uso de plaguicidas, por lo que crean sus propios bioinsumos para cuidar los cultivos.
“Recolectamos agua de lluvia para poder sembrar todas las semanas, tenemos un reservorio de un millón de litros de agua, hacemos nuestros abonos con muchos insumos de nuestra finca. También reproducimos nuestras semillas, tenemos un pequeño banco de semillas criollas”, mencionó Rodolfo Zamora, propietario de El Rinconcito Orgánico Irazú.

El Concepto
Este modelo de producción se puede considerar como bioeconomía circular, porque su origen y proceso facilita que se pueda realizar y utilizar una y otra vez el producto, como los bioinsumos que se crean con los recursos de las mismas fincas, se utilizan en la tierra y plantas del lugar y nuevamente se pueden utilizar esos elementos para crear más bioinsumos. Sin embargo, para muchos también existe la bioeconomía que no es circular.
“Algunos países han preferido utilizar el concepto de bioeconomía circular para enfocarse en el aumento de la eficiencia de los procesos productivos, transformación y comercialización que involucran recursos y principios biológicos, y en valorizar los desechos o residuos para producir insumos para la producción. Otros, han preferido utilizar el término más amplio de bioeconomía porque consideran que este incluye, la posibilidad de utilizar la biomasa primaria para agregar valor en cascada (como los biocombustibles)", explicó Hugo Chavarría del IICA.
Costa Rica carece de una certificación que reconozca a una empresa como parte del modelo de la bioeconomía. Federico Torres, director de investigación y desarrollo del Ministerio de Ciencia, Tecnología y Telecomunicaciones (Micitt), aseguró que en el desarrollo de la Estrategia Nacional de Bioeconomía que está trabajando la institución, se valorará la posibilidad de crear un certificado que identifique a las empresas con la estrategia.
Precisamente esa estrategia se está construyendo de manera interministerial, dirigida por el Micitt y apoyada por el Ministerio de Ambiente y Energía, de Agricultura y Ganadería (MAG) y el de Economía, Industria y Comercio (MEIC).
“Costa Rica encuentra en este modelo un gran valor y oportunidad en donde se genera un círculo virtuoso, tenemos toda una riqueza de biodiversidad, una concientización sobre el uso sostenible de los recursos biológicos, y capacidad científica y tecnológica para lograr la innovación”, detalló Luis Adrián Salazar, jerarca del Micitt.
Para el MEIC, la transformación productiva que genera la bioeconomía debe estar basada en tres ejes: el incremento en la agregación de valor, la diversificación y la sofisticación de los procesos productivos mediante el aprovechamiento sostenible los recursos de la biodiversidad, según lo explicó Óscar Quesada, funcionario de la Dirección de Investigaciones Económicas y Mercadeo.
Existen diez países que cuentan con estrategias dedicadas a la bioeconomía, entre los que están Alemania, Estados Unidos, España, Finlandia, Japón y Sudáfrica según Cepal. No obstante, en el 2017, el Consejo Alemán para la Bioeconomía identificó un total de 40 naciones que desarrollan estrategias relacionadas con este campo.

Por el momento el país carece de estadísticas sobre la bioeconomía o resultados de este modelo, solamente se cuenta con la capacitación y asesoramiento de instituciones como el IICA y la CEPAL. De igual manera, no se tiene un listado de la totalidad de empresas que desarrollan algún área bajo este esquema. La expectativa de las autoridades es que con la implementación de la estrategia se pueda contar en el futuro con documentación formal de resultados.
Otros casos
Empresa: Carnes Don Fernando
Actividad: Producción de carne de res premium.
Gestiones en bioeconomía: autocompensación en su finca al sustituir los fertilizantes sintéticos por fertilizantes orgánicos (bioinsumos) que ellos mismos elaboran, desarrollan prácticas de reforestación y conservación del suelo y el cuido de las fuentes de agua cercana al territorio de la finca.
Empresa: Coopedota
Actividad: Café
Gestiones en bioeconomía: con la broza del café generan compost, evitan el vertido de aguas que en ríos al usar lo que denominan como ferti-riego, que consiste en emplear en las plantaciones el agua utilizada en diferentes procesos.
Empresa: Finca Orgánica Santa Cecilia
Actividad: producción de frutas, verduras y pollo
Gestiones en bioeconomía: elaboración de abonos, biofermentos y extractos de plantas para combatir las plagas. Con el estiércol elaboran abono.